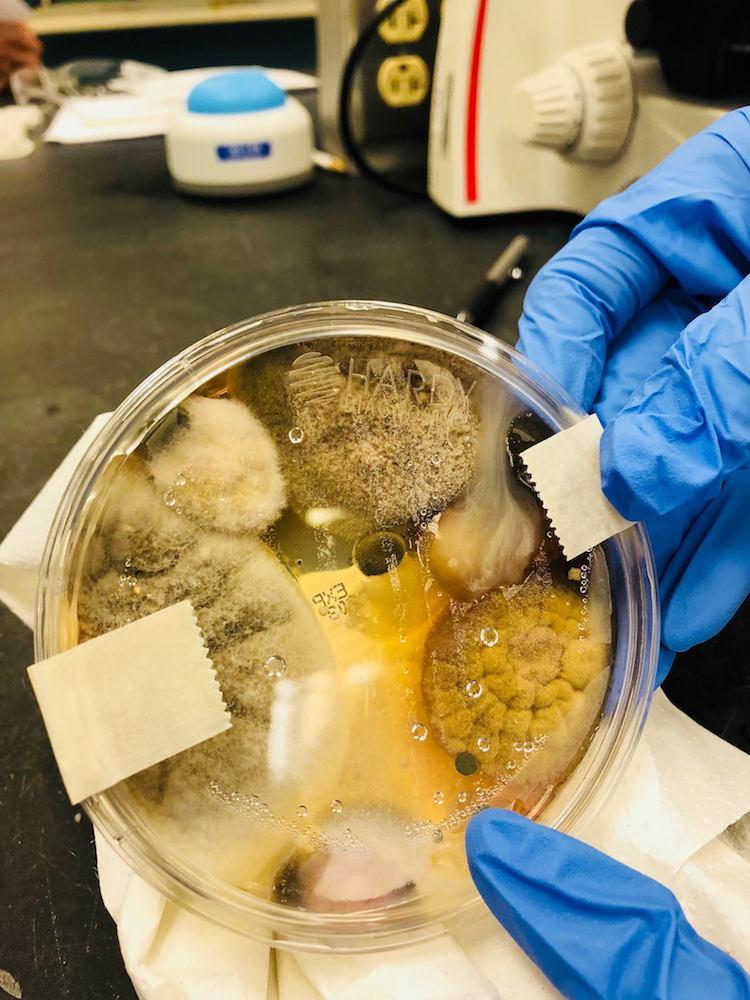

Les mains sales sont un nid à microbes et un réel problème d’hygiène qui préoccupe les médecins. Si on ne se lave pas assez les mains au quotidien, on ne sait pas bien les sécher non plus. Explications.Se laver les mains en sortant des toilettes n’est pas encore un réflexe majoritaire chez les Français. Pourtant, dans la plupart des toilettes des lieux publics, on trouve tout pour bien le faire. Une fois les mains lavées, la séquence d’hygiène ne s’arrête pas là : il faut les sécher. Avec 4 possibilités dont 2 seulement sont satisfaisantes pour les spécialistes des microbes.
Il faut fuir les solutions mises à votre disposition. La serviette est un nid à microbes, tout comme la plupart des dérouleurs, sans doute un peu moins contaminants mais souvent douteux. Le séchoir dans lequel on met ses mains, une autre méthode présentée comme résolument moderne, est en fait, selon des recherches récentes, un véritable piège à microbes, réchauffé chaque fois qu’on le met en marche.
Restent deux méthodes très acceptables : la serviette en papier, à condition de la jeter après emploi, ou l’air libre, qui est la meilleure solution, mais la plus longue et parfois la moins agréable lorsqu’il fait froid. Ce qui donne raison aux séchoirs où les mains restent à l'extérieur, ces accélérateurs de la méthode de séchage à l'air libre.
Les mains, notre principal outil de travail
Les mains sont notre principal outil et donc le plus exposé aux microbes qui nous entourent. Se laver les mains est simple et efficace. Pourtant, contrairement à ce que l’on pourrait croire, tous les efforts des instituteurs de la troisième République n’en ont pas fait un réflexe naturel. Loin s’en faut, puisqu’aujourd’hui, un enfant sur deux s’en moque. D’ailleurs, ils ne sont pas les seuls au monde, puisque l’on a organisé aussi la Journée mondiale de lavage des mains.
Même si cela fait un peu sourire et que l'on oublie souvent d’en parler, le plus gros progrès en termes de gain de vie au XXe siècle l’a été grâce à l’apparition de l’hygiène au quotidien. Et notamment des mains… Parce que l’on fait beaucoup de choses avec ses mains, et qu’elles ne sont jamais loin de la bouche.
50 % de maladies en moins
Par un lavage régulier au savon, le taux de morbidité infantile lié aux maladies diarrhéiques et aux pneumonies peut être réduit de moitié. Cela représente des milliers de vies épargnées… Et cela ne concerne pas que les pays émergents… Les virus de l’hiver vont se rappeler des mains sales de notre pays.
Autrefois, l’écolier savait que le sésame de la classe était paumes impeccables, levées vers le regard du maître. Ce n’est plus le cas. Demandez aux petits aujourd’hui si cela fait partie de leur vie quotidienne, ils hausseront les épaules en rigolant. Pourtant, les Français sont unanimes : ils souhaitent à 96 % avoir les mains propres, surtout les femmes et les personnes âgées. Entre 15 et 19 ans, ce n’est qu’un sur deux qui trouve l’affaire d’importance.
Inutile de céder à la mode des savons hors de prix
Il faut se laver les mains avec du savon liquide ou en gros bloc comme celui de Marseille, peu importe le moyen, pourvu qu’on le fasse.
Et ce n’est peut-être pas inutile de rappeler la méthode rapide idéale : on se mouille les mains ; on verse un peu de savon liquide dans le creux puis on se les frotte pendant au moins 20 secondes en les entrelaçant pour nettoyer entre les doigts. On pense aux ongles, on rince sous l’eau et on sèche avec un essuie-mains à usage unique que l’on jette après avoir essuyé le robinet avec. Cela, presque personne ne le fait alors que c’est important.
Au quotidien
Il faut se retrousser les manches et se laver les mains, chaque fois que l’on accomplit des gestes que l’on dit "à risque" comme se moucher, se gratter la tête, après avoir utilisé un téléphone public, en rentrant de l’école, du bureau, avant de manipuler des aliments, et bien évidemment en sortant des toilettes.